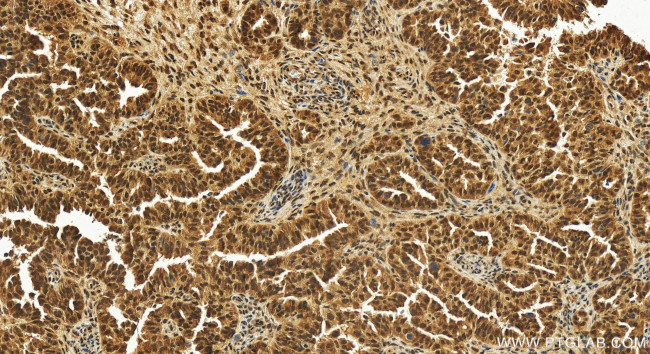
THOC3 Antibody in Immunohistochemistry (Paraffin) (IHC (P))

Search
Proteintech
THOC3 Polyclonal Antibody
{{$productOrderCtrl.translations['antibody.pdp.commerceCard.promotion.promotions']}}
{{$productOrderCtrl.translations['antibody.pdp.commerceCard.promotion.viewpromo']}}
{{$productOrderCtrl.translations['antibody.pdp.commerceCard.promotion.promocode']}}: {{promo.promoCode}} {{promo.promoTitle}} {{promo.promoDescription}}. {{$productOrderCtrl.translations['antibody.pdp.commerceCard.promotion.learnmore']}}
产品信息
11716-1-AP
种属反应
宿主/亚型
分类
类型
抗原
偶联物
形式
浓度
规格
纯化类型
保存液
内含物
保存条件
运输条件
产品详细信息
Immunogen sequence: MAVPAAAMGP SALGQSGPGS MAPWCSVSSG PSRYVLGMQE LFRGHSKTRE FLAHSAKVHS VAWSCDGRRL ASGSFDKTAS VFLLEKDRLV KENNYRGHGD SVDQLCWHPS NPDLFVTASG DKTIRIWDVR TTKCIATVNT KGENINICWS PDGQTIAVGN KDDVVTFIDA KTHRSKAEEQ FKFEVNEISW NNDNNMFFLT NGNGCINILS YPELKPVQSI NAHPSNCICI KFDPMGKYFA TGSADALVSL WDVDELVCVR CFSRLDWPVR TLSFSHDGKM LASASEDHFI DIAEVETGDK LWEVQCESPT FTVAWHPKRP LLAFACDDKD GKYDSSREAG TVKLFGLP
靶标信息
THOC3 is part of the TREX (transcription/export) complex, which includes THO2, HPR1, ALY, and UAP56.TEX1 is part of the TREX (transcription/export) complex, which includes THO2, HPR1, ALY, and UAP56.
仅用于科研。不用于诊断过程。未经明确授权不得转售。
篇参考文献 (0)
生物信息学
蛋白别名: hTREX45; TEX1; TEX1 homolog; THO complex 3; THO complex subunit 3; Tho3
基因别名: hTREX45; THO3; THOC3
UniProt ID: (Human) Q96J01
Entrez Gene ID: (Human) 84321